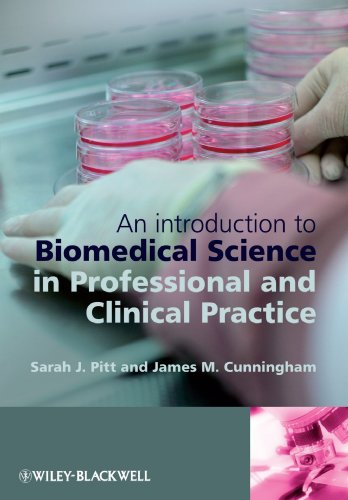

Looking for Biomedical Science Practice: experimental and professional skills (Fundamentals of Biomedical Science) Lowest Prices
Hurry Up!!!! this is limited time offer
Sale now on
Biomedical Science Practice: experimental and professional skills (Fundamentals of Biomedical Science)
Biomedical Science Practice: experimental and professional skills (Fundamentals of Biomedical Science) Cheap Price and Lowest Price
Biomedical Science Practice: experimental and professional skills (Fundamentals of Biomedical Science) Review and Overviews
If you Find Biomedical Science Practice: experimental and professional skills (Fundamentals of Biomedical Science) cheapest price .This is reviews and overviews for Biomedical Science Practice: experimental and professional skills (Fundamentals of Biomedical Science).
Biomedical scientists are the foundation of modern healthcare, from cancer screening to diagnosing HIV, from blood transfusion for surgery to food poisoning and infection control. Without biomedical scientists, the diagnosis of disease, the evaluation of the effectiveness of treatment, and research into the causes and cures of disease would not be possible.
The
Fundamentals of Biomedical Science series is written to reflect the challenges of practicing biomedical science today. It draws together essential basic science with insights into laboratory practice to show how an understanding of the biology of disease is coupled to the analytical approaches that lead to diagnosis.
Assuming only a minimum of prior knowledge, the series reviews the full range of disciplines to which a Biomedical Scientist may be exposed - from microbiology to cytopathology to transfusion science. Alongside volumes exploring specific biomedical themes and related laboratory diagnosis, an overarching Biomedical Science Practice volume gives a grounding in the professional and experimental skills with which any Biomedical Scientist must be equipped.
The series
DT Understands the complex roles of Biomedical Scientists in the modern practice of medicine.
DT Understands the development needs of employers and the Profession.
DT Addresses the need for understanding of a range of fundamental sciences in the context of Biomedicine.
DT Places the theoretical aspects of Biomedical Science in their practical context.
Biomedical Science Practice presents the essential practical and professional skills that every biomedical scientist should master, making it the perfect foundation for the study of each of the key subject specialisms that maybe encountered in the biomedical lab.
The book reviews a broad range of professional skills and concepts, including health and safety considerations, personal development, and communication, and also introduces the key experimental and analytical approaches that form the basis of the investigation and diagnosis of clinical conditions.
Drawing on the wealth of experience of a range of biomedical science practitioners and educators,
Biomedical Science Practice is the ideal companion throughout your biomedical science education and training.
Online Resource Centre The Online Resource Centre to accompany
Biomedical Science Practice features:
For registered adopters of the book:
DT Figures from the book, available to download
For students:
DT An interactive Digital Microscope, encouraging the exploration of tissue samples
DT Self-assessment modules to help you to check and reinforce understanding of the basic science introduced in each volume
DT Video podcasts including interviews with practicing biomedical scientists, and 'in the lab' footage showing biomedical science in practice
and then update cheapest prices immediately. Limited time Only!